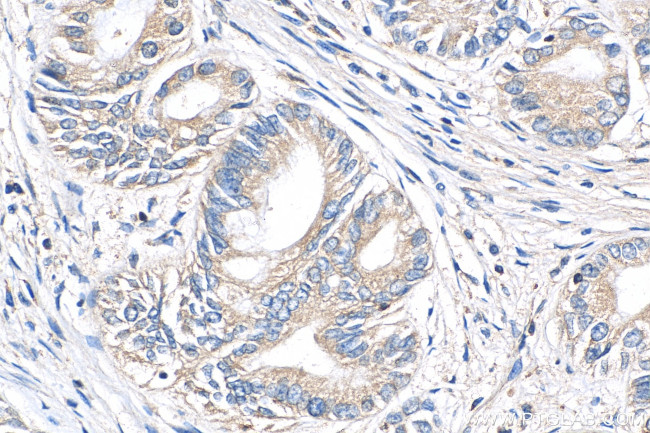
PIP4K2B Antibody in Immunohistochemistry (Paraffin) (IHC (P))

Search
Proteintech
PIP4K2B Polyclonal Antibody
{{$productOrderCtrl.translations['antibody.pdp.commerceCard.promotion.promotions']}}
{{$productOrderCtrl.translations['antibody.pdp.commerceCard.promotion.viewpromo']}}
{{$productOrderCtrl.translations['antibody.pdp.commerceCard.promotion.promocode']}}: {{promo.promoCode}} {{promo.promoTitle}} {{promo.promoDescription}}. {{$productOrderCtrl.translations['antibody.pdp.commerceCard.promotion.learnmore']}}










Please note: We are reviewing Western blot images included in the antibody testing data in our catalog, including those provided by third parties. Unless expressly labeled or annotated as “raw-unedited”, Western blot images included in the antibody testing data in our catalog may have been edited, optimized or otherwise adjusted for presentation.
产品信息
13218-1-AP
种属反应
已发表种属
宿主/亚型
分类
类型
抗原
偶联物
形式
浓度
规格
纯化类型
保存液
内含物
保存条件
运输条件
产品详细信息
Immunogen sequence: MSSNCTSTT AVAVAPLSAS KTKTKKKHFV CQKVKLFRAS EPILSVLMWG VNHTINELSN VPVPVMLMPD DFKAYSKIKV DNHLFNKENL PSRFKFKEYC PMVFRNLRER FGIDDQDYQN SVTRSAPINS DSQGRCGTRF LTTYDRRFVI KTVSSEDVAE MHNILKKYHQ FIVECHGNTL LPQFLGMYRL TVDGVETYMV VTRNVFSHRL TVHRKYDLKG STVAREASDK EKAKDLPTFK DNDFLNEGQK LHVGEESKKN FLEKLKRDVE EILVLSPGRR IA (1-281 aa encoded by BC027459)
靶标信息
The protein encoded by this gene catalyzes the phosphorylation of phosphatidylinositol-5-phosphate on the fourth hydroxyl of the myo-inositol ring to form phosphatidylinositol-5,4-bisphosphate. This gene is a member of the phosphatidylinositol-5-phosphate 4-kinase family. The encoded protein sequence does not show similarity to other kinases, but the protein does exhibit kinase activity. Additionally, the encoded protein interacts with p55 TNF receptor.
仅用于科研。不用于诊断过程。未经明确授权不得转售。
生物信息学
蛋白别名: 1-phosphatidylinositol 5-phosphate 4-kinase 2-beta; 1-phosphatidylinositol-5-phosphate 4-kinase 2-beta; 1-phosphatidylinositol-5-phosphate 4-kinase B; Diphosphoinositide kinase 2-beta; Phosphatidylinositol 5-phosphate 4-kinase type II beta; Phosphatidylinositol 5-phosphate 4-kinase type-2 beta; phosphatidylinositol-4-phosphate 5-kinase, type II, beta; phosphatidylinositol-5-phosphate 4-kinase type-2 beta; Phosphatidylinositol-phosphate kinase IIgamma; PI(5)P 4-kinase type II beta; PIP4KII-beta; PIPKIIgamma; PtdIns(5)P-4-kinase isoform 2-beta
基因别名: AI848124; c11; PI5P4Kbeta; Pip4k2b; Pip5k2b
UniProt ID: (Rat) O88377, (Mouse) Q80XI4
Entrez Gene ID: (Rat) 89812, (Mouse) 108083